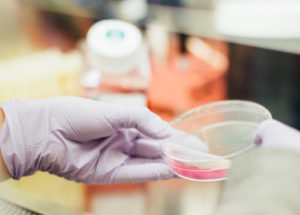
researcher holiday a dish fill with medications

Hey Doc!™: A new service to help you cope with COVID-19
Hey Doc!™: A new service to help you cope with COVID-19 Read More →
Resources
Get support on your schedule, free tools you can access anytime, and insights from people who’ve been there.
Live Events
Online and in-person educational workshops, featuring an array of expert partners covering topics no one else does.
Not just Parkinson’s—all movement disorders, all perspectives. There’s a place for you here.
For physicians, APPs, and long-term care professionals—explore accredited education, community research, and free patient resources.
We’re not like the big guys. You come to us with a problem, and we partner with you to solve it.
New look, same Alliance. Learn more about our rebrand here.
New look, same Alliance.
Would you consider switching to a $20/month contribution? Your ongoing support helps us focus on serving the movement disorders community.
Entering your card details allows us to process your donation. This card will be charged.
$0.00 USD one-time
Covering the transaction fee allows us to receive 100% of your gift!
Your donation has been processed successfully.
Your payment could not be processed. Please review the payment details, and try again.
Your support connects and empowers everyone impacted by movement disorders. Learn more about reasons for giving here.
Processing your donation…